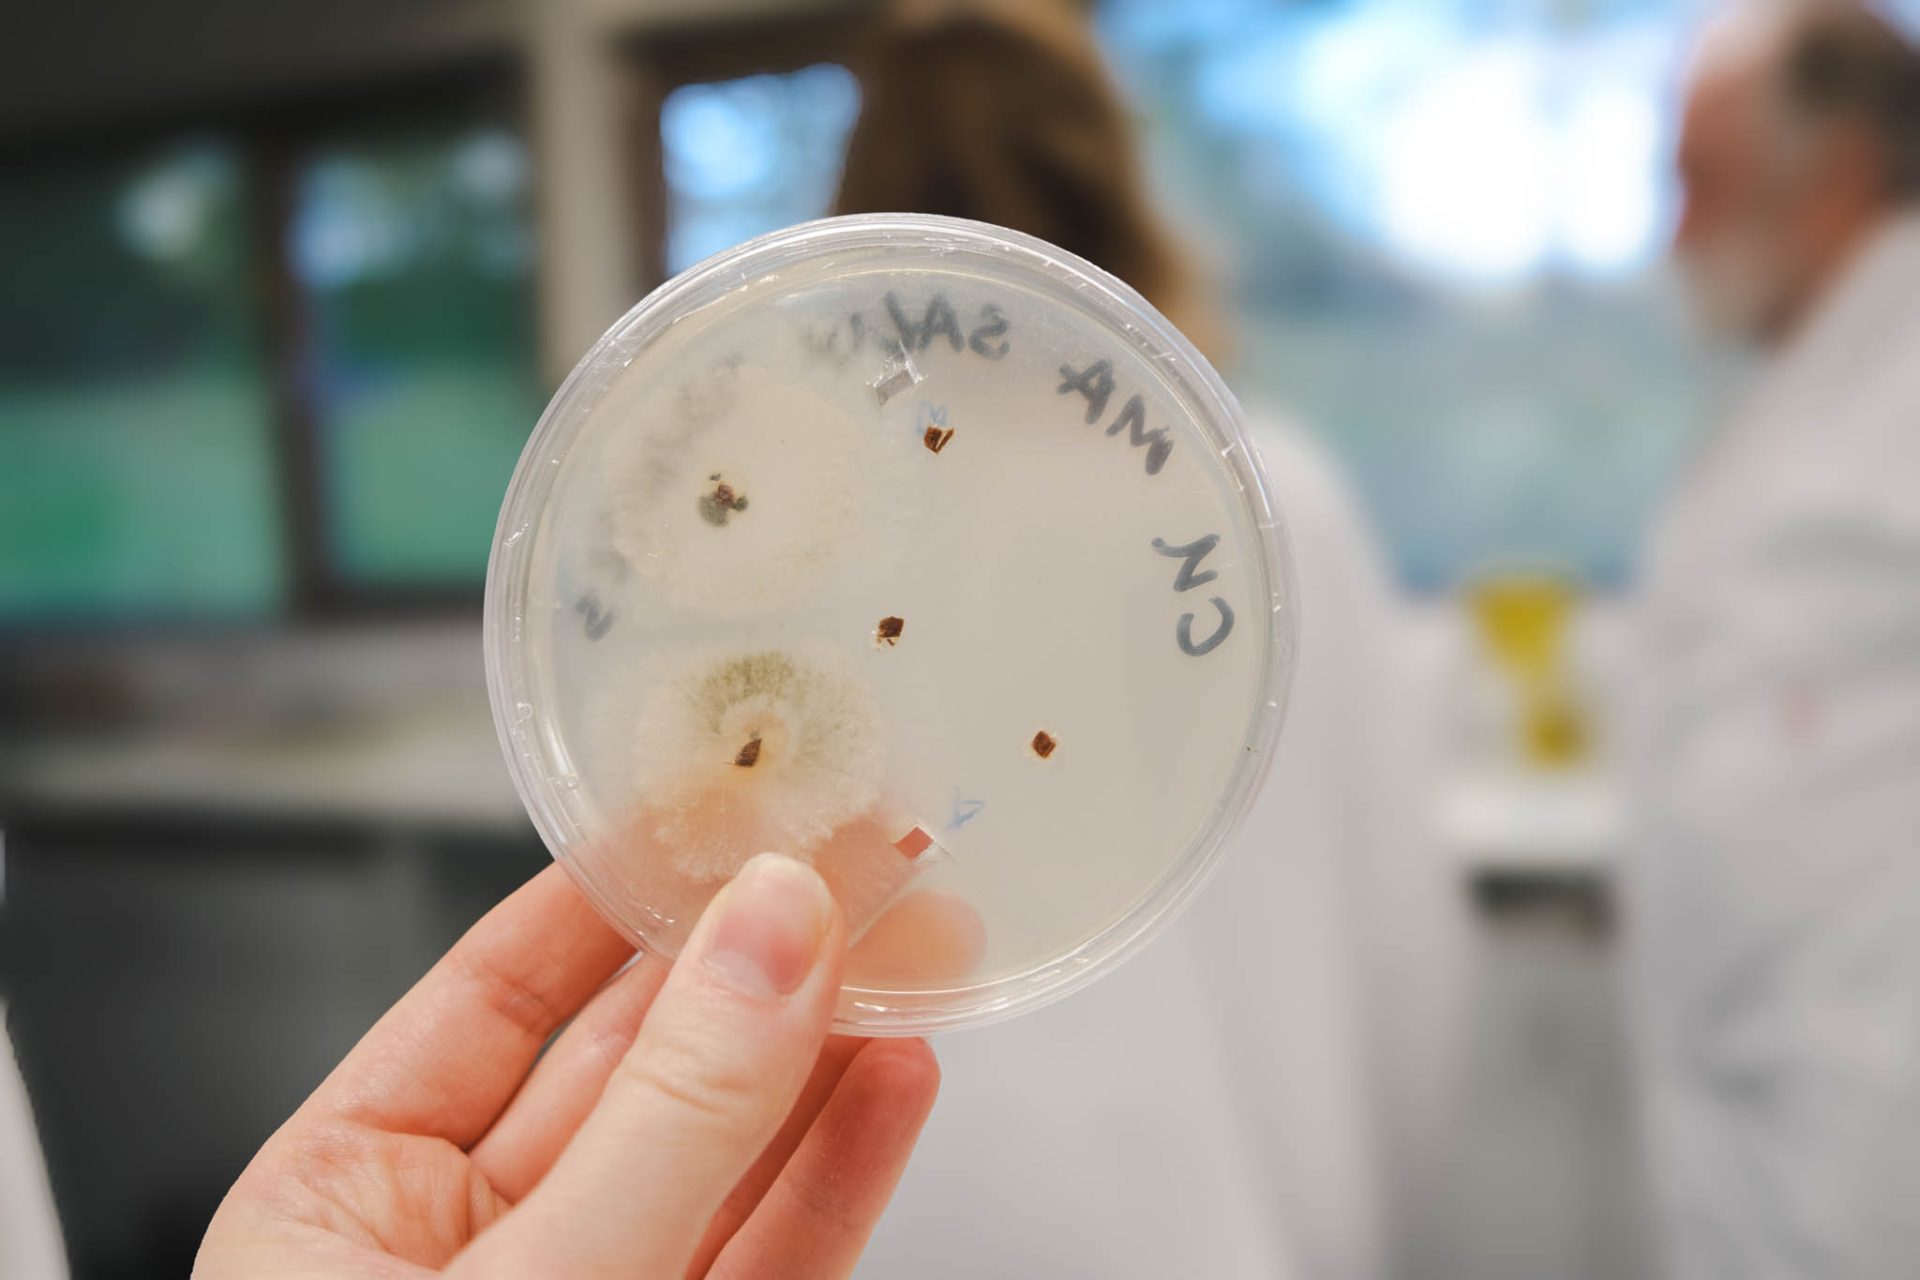
Petri dish showing growth of pathogen.

Observatree volunteers recently joined us for a hands-on day learning how to identify key tree pests and diseases. Through a mix of training sessions, expert talks and lab tours, participants explored how to recognise symptoms in the field, report them through TreeAlert, and how to collect and submit samples to the Tree Health Diagnostic Advisory service.
The day was also a valuable opportunity for volunteers to meet members of the Tree Health Diagnostics team and see how their vital role fits into the bigger picture of protecting the UK’s trees.
Observatree is a collaborative partnership whose members include The Woodland Trust and several other key organisations working together to safeguard the UK’s trees and woodlands by connecting science with citizen action.
See how the day unfolded in our photo essay below, and a big thank-you to everyone who took part and to all the teams who made the sessions so engaging and informative.










infestation was discovered. Damage caused by Asian longhorn beetle larva can be seen inside log.

Recent News
View All news
Provisional woodlands statistics released
On Wednesday 17 June, Forest Research was admitted to the European National Forest Inventory Network (ENFIN).
Provisional woodlands statistics released
On Wednesday 17 June, Forest Research was admitted to the European National Forest Inventory Network (ENFIN).